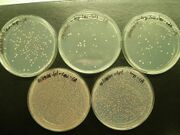

Uploads by Emre Deniz
From OpenWetWare
Jump to navigationJump to search
This special page shows all uploaded files.
| Date | Name | Thumbnail | Size | Description |
|---|---|---|---|---|
| 12:11, 18 October 2009 | DroppedImage.png (file) |  |
36 KB | |
| 12:10, 18 October 2009 | 2A ST293 (NFAT2) (-) F 40 X.jpg (file) |  |
25 KB | |
| 12:09, 18 October 2009 | Picture 033.jpg (file) | |
56 KB | |
| 12:04, 18 October 2009 | Composite.jpg (file) |  |
56 KB |